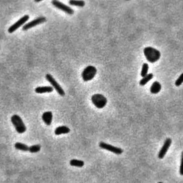
Swim-Substack (1-1001-3).gif

ARCHAEA AS A MODEL FOR
EVO-DEVO MECHANOPLASTICITY
"The definition of life might be stated simply as that which is squishy" – Gerald F. Joyce. The RNA World
The Bisson Lab focuses on the intersection between microbial mechanobiology and evolution. We comprise a cross-disciplinary team of biologists and physicists investigating how cells self-organize and evolve in response to mechanical forces.


The vast majority of cellular life we know of evolved to carry a rigid cell wall many times thicker than the cytoplasmic membrane. Among the exceptions, the Archaea are the group of organisms that are more consistently devoid of a cell wall. Curiously, Archaea are also the closest prokaryotic (no nucleus enveloping the genetic material) microorganisms to Eukaryotes. It is believed that this "squishy" feature of Archaea played a pivotal role in the emergence of Eukaryotic cells.
Low-resolution tree of life representing the distribution and divergence between Bacteria, Eukaryotes, and Archaea. The different archaeal superphyla are represented in green. Illustration adapted from Eme et al., 2017
Nonetheless, archaeal cells must sense and respond to survive mechanical forces by quickly organize cargo to create and propagate new patterns. We propose that the viscoelastic nature of archaea facilitated the emergence of plastic traits through active polymeric and mechanoresponsive systems.

Currently, the Bisson Lab has been working on a number of topics surrounding the mechanobiology of dozens of salt-loving archaeal species. Haloarchaea are known for their diversity of unusual morphologies across evolutionarily related species. How they assemble pleomorphic, often polygonal shapes without a rigid envelope has been in debate for over 50 years but still unknown.

Shape plasticity is a hallmark of mechanosensation. Moreover, many haloarcheal species are able to readout biochemical and mechanical stimuli to orchestrate reversible transitions to different cell types, including rods (swimmers), polygons (sessile, biofilm producers)
We are not only interested in how cells acquire specific shapes, but in the processes driving the transitions between developmental states, such as rod-disk shape-shift [Curtis et al., 2024] and tissue-like, multicellular [Rados et al., 2025] lifestyles.


Every squishy cell ever studied has shown, in one or another, the ability to respond to specific mechanical perturbations. We are interested in exploring how archaeal cells respond to numberless physical challenges like confinement, shear, osmotic shocks, and temperature. Using established and unpublished cutting-edge live-cell single-molecule tracking, we investigate how the peculiar haloarchaeal viscoelastic properties shaped the molecular mechanisms of cytoskeletal function and sub-cellular organization across a variety of cellular processes, including in the molecular biology dogma (replication, transcription, and translation), cell division, and cell size and growth
Cytoplasm
NANORHEOLOGY

membrane
NANORHEOLOGY

CELL DIVISION

DNA REPLICATION
